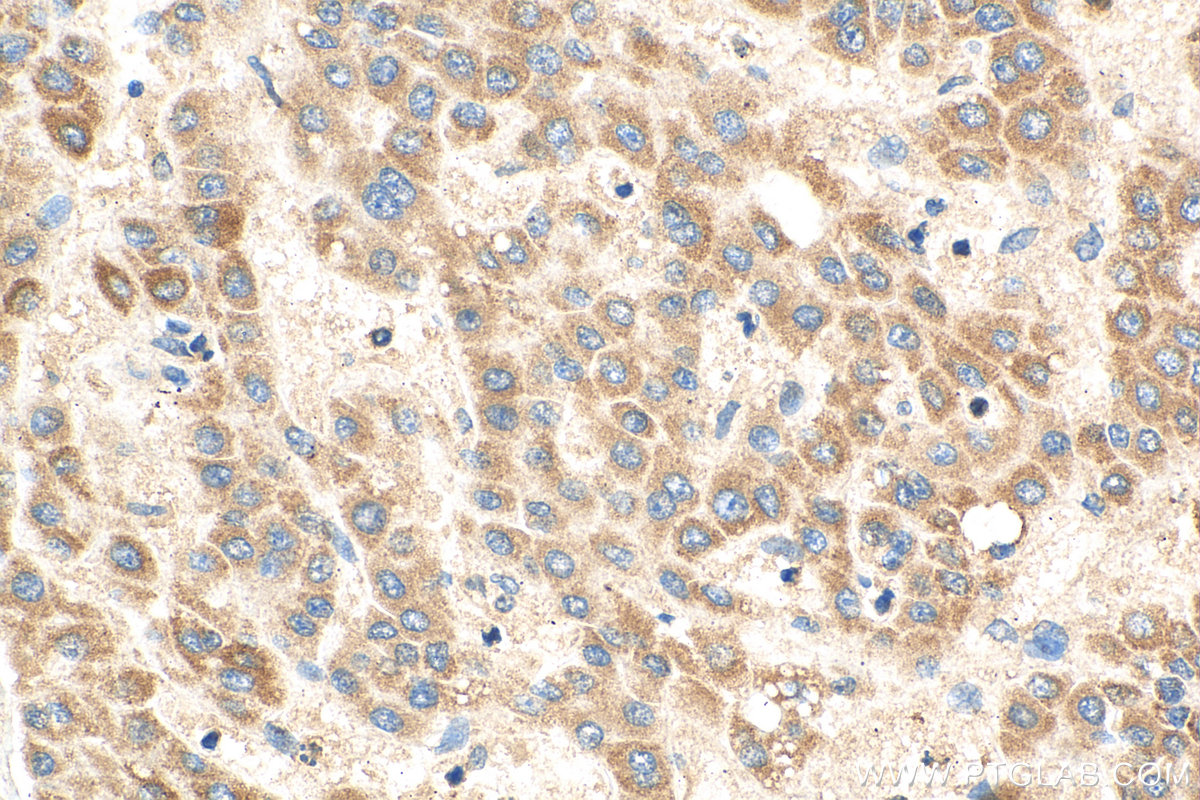

验证数据展示
经过测试的应用
| Positive WB detected in | A549 cells, HeLa cells, HepG2 cells, MCF-7 cells |
| Positive IHC detected in | human lung cancer tissue, human breast cancer tissue, human liver cancer tissue Note: suggested antigen retrieval with TE buffer pH 9.0; (*) Alternatively, antigen retrieval may be performed with citrate buffer pH 6.0 |
| Positive IF/ICC detected in | MCF-7 cells |
推荐稀释比
| 应用 | 推荐稀释比 |
|---|---|
| Western Blot (WB) | WB : 1:2000-1:14000 |
| Immunohistochemistry (IHC) | IHC : 1:1000-1:4000 |
| Immunofluorescence (IF)/ICC | IF/ICC : 1:200-1:800 |
| It is recommended that this reagent should be titrated in each testing system to obtain optimal results. | |
| Sample-dependent, Check data in validation data gallery. | |
产品信息
28445-1-AP targets PGAM5 in WB, IHC, IF/ICC, CoIP, ELISA applications and shows reactivity with Human samples.
| 经测试应用 | WB, IHC, IF/ICC, ELISA Application Description |
| 文献引用应用 | WB, IHC, IF, CoIP |
| 经测试反应性 | Human |
| 文献引用反应性 | human, mouse, pig, goat, sheep |
| 免疫原 |
CatNo: Ag28195 Product name: Recombinant human PGAM5 protein Source: e coli.-derived, PET28a Tag: 6*His Domain: 1-255 aa of BC008196 Sequence: MAFRQALQLAACGLAGGSAAVLFSAVAVGKPRAGGDAEPRPAEPPAWAGGARPGPGVWDPNWDRREPLSLINVRKRNVESGEEELASKLDHYKAKATRHIFLIRHSQYHVDGSLEKDRTLTPLGREQAELTGLRLASLGLKFNKIVHSSMTRAIETTDIISRHLPGVCKVSTDLLREGAPIEPDPPVSHWKPEAVQYYEDGARIEAAFRNYIHRADARQEEDSYEIFICHANVIRYIVCSIPPLLSAGDFVVLGS 种属同源性预测 |
| 宿主/亚型 | Rabbit / IgG |
| 抗体类别 | Polyclonal |
| 产品类型 | Antibody |
| 全称 | phosphoglycerate mutase family member 5 |
| 别名 | BXLBv68, PGAM5 |
| 计算分子量 | 32 kDa |
| 观测分子量 | 32 kDa |
| GenBank蛋白编号 | BC008196 |
| 基因名称 | PGAM5 |
| Gene ID (NCBI) | 192111 |
| RRID | AB_2881143 |
| 偶联类型 | Unconjugated |
| 形式 | Liquid |
| 纯化方式 | Antigen affinity purification |
| UNIPROT ID | Q96HS1 |
| 储存缓冲液 | PBS with 0.02% sodium azide and 50% glycerol, pH 7.3. |
| 储存条件 | Store at -20°C. Stable for one year after shipment. Aliquoting is unnecessary for -20oC storage. |
背景介绍
Phosphoglycerate mutase 5 (PGAM5) is a mitochondrial Serine (Ser)/Threonine (Thr) phosphatase normally located in the inner mitochondrial membrane. Upon mitochondrial dysfunction, PGAM5 recruits and dephosphorylates Drp1 at Ser-637, triggers its GTPase activity and promotes mitochondrial fission. PGAM5 regulates mitophagy by stabilizing PINK1 under stress conditions, which recruits E3 ubiquitin ligase PARKIN for degradation of the damaged mitochondria. PGAM5 can be cleaved and released to the cytoplasm through PARKIN, which activates Wnt signaling and induces mitochondrial biogenesis (PMID: 32439975). PGAM5 has 2 isoforms with the molecular mass of 28 and 32 kDa.
实验方案
| Product Specific Protocols | |
|---|---|
| IF protocol for PGAM5 antibody 28445-1-AP | Download protocol |
| IHC protocol for PGAM5 antibody 28445-1-AP | Download protocol |
| WB protocol for PGAM5 antibody 28445-1-AP | Download protocol |
| Standard Protocols | |
|---|---|
| Click here to view our Standard Protocols |
发表文章
| Species | Application | Title |
|---|---|---|
Cell Biosci Differential effects of PGAM5 knockout on high fat high fructose diet and methionine choline-deficient diet induced non-alcoholic steatohepatitis (NASH) in mice | ||
Int J Mol Sci The Mitochondrial PHB2/OMA1/DELE1 Pathway Cooperates with Endoplasmic Reticulum Stress to Facilitate the Response to Chemotherapeutics in Ovarian Cancer. | ||
Int Immunopharmacol 4-Octyl itaconate inhibits inflammation to attenuate psoriasis as an agonist of oxeiptosis | ||
J Virol PGAM5 degrades PDCoV N protein and activates type I interferon to antagonize viral replication | ||
Biochim Biophys Acta Mol Cell Res Tau phosphorylation and OPA1 proteolysis are unrelated events: Implications for Alzheimer's Disease. | ||
Heliyon LFHP-1c improves cognitive function after TBI in mice by reducing oxidative stress through the PGAM5-NRF2-KEAP1 ternary complex |